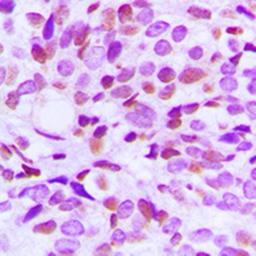
Immunohistochemical analysis of formalin-fixed and paraffin-embedded human breast cancer tissue using BRAF35 antibody

Product & ReviewsAntibodies
Histone H4 (AcK16) antibody
Product Details
- Cat. No.
- orb256601
- Type
- Primary Antibody
- Clonality
- Polyclonal
- Host
- Rabbit

The supplier does not provide quotations for this antibody through SelectScience. You can search for similar antibodies in our Antibody Directory.
Description
Rabbit polyclonal antibody to Histone H4 (AcK16)
Biological Information
- Clonality: Polyclonal
- Host: Rabbit
- Reactivity: Cat (Feline), Human, Mammalian, Mouse, Pig (Swine)
- Isotype: IgG
- Gene: 4437
Handling
- Quantity: 200 µl, 30 µl (Trial size), 100 µl
- Storage: Store at 4°C. Upon delivery aliquot and store at -20°C for one year. Avoid freeze/thaw cycles.
- Buffer: Liquid in 0.42% Potassium phosphate, 0.87% Sodium chloride, pH 7.3, 30% glycerol, and 0.01% sodium azide.
Applications
- Immunofluorescence (Paraffin-Embedded Sections) (IF (P))
- Immunohistochemistry (Paraffin-Embedded Sections) (IHC (P))
- Western Blotting (WB)